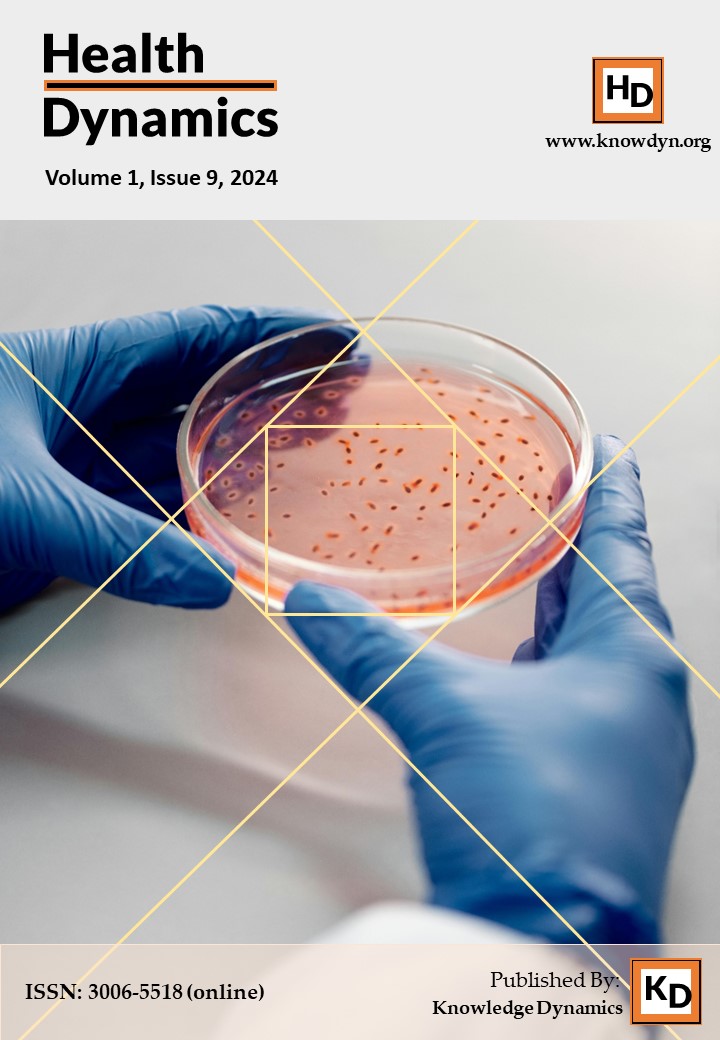
Cover Page

2026
This is an upcoming issue. We are still receiving manuscripts for this issue. Please submit earlier.
This issue is in progress. New articles will be added to this issue as soon as they are ready to be published.
This issue consists of 6 articles contributed by 20 authors affiliated with 11 institutions from 2 countries, including Indonesia (Gedung Karya Jitu Health Centre, Lampung; Institute Kesehatan Rajawali, Bandung; Politeknik Kesehatan Kementerian Kesehatan Surabaya; Poltekkes Kemenkes Malang; Regional Board of Muhammadiyah Student Association (IMM) Central Java; RSUD Dr Moewardi, Surakarta; Soegijapranata Catholic University; Universitas Mitra Indonesia, Lampung; Universitas Muhammadiyah Purwokerto; Universitas Sebelas Maret, Surakarta) and Bangladesh.
This issue consists of 6 articles contributed by 22 authors affiliated with more than 12 institutions from 3 countries including Bangladesh (Chattogram Veterinary and Animal Sciences University; North South University; University of Dhaka; University of Chittagong, Chattogram), Indonesia (Mitra University Indonesia, Lampung; Poltekkes Kemenkes Denpasar, Bali; Politeknik Kesehatan Kementerian Kesehatan Surabaya; Muhammadiyah University of Jember; University of Jember), and Yemen (Taiz University, Taiz; University of Saba Region, Marib; University of Science & Technology, Aden)
This issue consists of 6 articles contributed by 20 authors affiliated with more than 11 institutions from 3 countries including Indonesia (Health Polytechnic Ministry of Health, Surabaya; IAKMI East Java Regional Office, Surabaya; Ibrahimy University, Situbondo; Poltekkes Kemenkes Palangka Raya; Research Group for health and well-being of Women & Children; Situbondo Regency Health Office, Situbondo Regency; Ummi University, Bogor; Universitas Airlangga, Banyuwangi; Universitas Jember, University of Indonesia), Sierra Leone (Directorate of Environmental Health and Climate Health, Ministry of Health), and Bangladesh
This issue consists of 6 articles contributed by 25 authors affiliated with more than 8 institutions from 4 countries including Indonesia (Health Polytechnic Ministry of Health, Surabaya; Poltekkes Kemenkes Yogyakarta; Ummi University, Bogor; Universitas Airlangga; University of Jember), Pakistan (Government College University Faisalabad), Sierra Leone (Directorate of Environmental Health and Climate Health, Ministry of Health), and Bangladesh
2025
This issue consists of 6 articles contributed by 21 authors affiliated with more than 6 institutions from 4 countries including Bangladesh (Chattogram Veterinary and Animal Sciences University), Indonesia (Sekolah Tinggi Ilmu Kesehatan Mitra Husada Medan; Universitas Darussalam Gontor), Pakistan (Government College University Faisalabad; University of Agriculture Faisalabad), and USA (University of Hawaii, Manoa)
This issue consists of 6 articles contributed by 18 authors affiliated with more than 11 institutions from 3 countries including Indonesia (PGRI University Sumenep; Politeknik Baubau; STIKes Mitra Husaa Medan; Universitas Airlangga; Universitas Islam Kalimantan MAB; Universitas Mandala Waluya; Wiraraja University), Pakistan (Government College University Faisalabad; International Institute of Art Science and Technology, Gujranwala; University of Agriculture Faisalabad), and Bangladesh.
This issue consists of 6 articles contributed by 37 authors affiliated with more than 11 institutions from 4 countries including Australia (Swinburne University of Technology, Victoria), Indonesia (Indriati Boyolali Hospital, Boyolali; Poltekkes Kemenkes Denpasar; Poltekkes Kemenkes Palu; Poltekkes Kemenkes Semarang; Poltekkes Kemenkes Surabaya; Poltekkes Kemenkes Yogyakarta; Universitas Ibnu Sina, Batam), Malaysia (AIMST University; Universiti Sains Malaysia), and Bangladesh.
This issue consists of 6 articles contributed by 23 authors affiliated with more than 11 institutions from 5 countries including China (Kunming University of Science and Technology), Bangladesh (Bangladesh Council of Scientific and Industrial Research (BCSIR); Chattogram Veterinary and Animal Sciences University (CVASU); Daffodil International University; Maternal and Child Health and Nutrition Research Project of Johns Hopkins University (Bangladesh)), Indonesia (Poltekkes Kemenkes Surabaya; Universitas Airlangga, Surabaya; Universitas Gadjah Mada), Malaysia (Universiti Teknologi MARA), and New Zealand (University of Otago).
This issue consists of 6 articles contributed by 25 authors affiliated with more than 9 institutions from 4 countries including Australia (Swinburne University of Technology, Victoria), Indonesia (Indriati Boyolali Hospital, Boyolali; Institut Teknologi Sains dan Kesehatan Rs. dr. Soepraoen Malang; Poltekkes Kemenkes Yogyakarta; Universitas Airlangga, Surabaya; Universitas Mitra Indonesia, Bandar Lampung; Universitas Muhammadiyah Surakarta; Universitas Nahdlatul Ulama, Surabaya), Malaysia (Universiti Putra Malaysia), and Bangladesh.
This issue consists of 6 articles contributed by 30 authors affiliated with more than 11 institutions from 5 countries including Bangladesh (Chattogram Veterinary and Animal Sciences University; Sher-e-Bangla Agricultural University), Indonesia (Institut Teknologi Sains dan Kesehatan Rs. dr. Soepraoen Malang, Muhammadiyah University of Madiun; Universitas Airlangga, Surabaya; Universitas Islam Kalimantan MAB Banjarmasin, Banjarmasin; Universitas Mandala Waluya, Kendari; Universitas Mitra Indonesia, Bandar Lampung), Italy (Universita degli Studi di Milano, Lodi), Kingdom of Saudi Arabia (Al Arkkan Training and Education Company, Ministry of Municipal, Rural Affairs and Housing), and United States (University of Hawaii, Manoa)
This issue consists of 7 articles contributed by 37 authors affiliated several institutions including Institute of Technology, Science, and Health RS dr. Soepraoen, Malang, Indonesia; Ministry of Health Polytechnic, Denpasar, Indonesia; Polteknik Kesehatan Kemenkes Denpasar, Indonesia; Politeknik Kesehatan Kementerian Kesehatan Surabaya, Indonesia; Universitas Airlangga, Indonesia; Universitas Mitra Indonesia
This issue consists of 6 articles contributed by 30 authors affiliated with more than 11 institutions from 6 countries including India (TMM College of Nursing, Kerala), Indonesia (Jember University Dental Hospital, Jember; Muhammadiyah University of Madiun; Politeknik Kesehatan Kementerian Kesehatan Surabaya; UMMI University, Bogor; University of Jember), United Kingdom (Greater Manchester Mental Health NHS Foundation Trust, Manchester), United States (University of Hawaii, Manoa, USA), Vietnam (Hanoi Medical University; FPT Long Chau Pharma, Hanoi; Vietnam Public Health Association, Hanoi), and Bangladesh
This issue consists of 6 articles contributed by 31 authors affiliated with more than 10 institutions from 5 countries including Indonesia (Airlangga University; Institut Ilmu Kesehatan Bhakti Wiyata Kediri; Ministry of Health Polytechnic Surabaya; Noor Huda Mustofa University), Sierra Leone (Ministry of Health, Sierra Leone), United Kingdom (University College London), Vietnam (Hanoi Medical University; Health Strategy and Policy Institute, Hanoi; Vietnam Public Health Association, Hanoi), and Bangladesh
This issue consists of 6 articles contributed by 30 authors affiliated with more than 14 institutions from 5 countries including Bangladesh (Dhaka Medical College Hospital), Indonesia (Airlangga University; Brawijaya University; DR Iskak Regional Public Hospital, Tulungagung; Ministry of Health Polytechnic, Denpasar; University of Muhammadiyah Malang, Universitas Mitra Indonesia), Malaysia (Hospital Rehabilitasi Cheras, Kuala Lumpur; Universiti Teknologi MARA, Cawangan Pulau Pinang, Bertam Campus), United Kingdom (University College London), and Vietnam (FPT Long Chau Pharma, Hanoi; Hanoi Medical University; Health Strategy and Policy Institute, Hanoi; Tam Anh General Hospital, Hanoi; Vietnam Public Health Association, Hanoi)
This issue consists of 6 articles contributed by 31 authors affiliated with more than 11 institutions from 4 countries including Indonesia (Ministry of Health Polytechnic, Denpasar; Politeknik Bau-Bau; Politeknik Kesehatan Kementerian Kesehatan Surabaya; Universitas Airlangga; Universitas Islam Kalimantan MAB; Universitas Mandala Waluya), Malaysia (Universiti Malaysia Terengganu; Universiti Sains Malaysia; Universiti Teknologi MARA, Bertam Campus), United States of America (University of North Texas), and Bangladesh
This special issue is a supplement to the annual conference of the Ministry of Health Polytechnic Surabaya (Poltekkes Kemenkes Surabaya) in 2024. It consists of 11 articles contributed by 23 authors.
This issue consists of 6 articles contributed by 22 authors affiliated with more than 14 institutions from 4 countries including Indonesia (Airlangga University; Brawijaya University; Center of Excellence for Applied Technology Innovation in The Field of Public Health (PUI_Novakesmas), Sleman; Dr. Iskak Regional Public Hospital, Tulungagung; Kristen Kirda Wacana University; Poltekkes Kemenkes Yogyakarta; RSUD Dr. H. Abdul Moeloek Provinsi Lampung; Sleman Regional General Hospital, Yogyakarta; Universitas Ahmad Dahlan; Universitas Mitra Indonesia; Universitas Sebelas Maret), Iraq (Al-Taff University College, Karbala), United Kingdom (Moorfields Eye Hospital, University College London), and Bangladesh
2024
This issue consists of 7 articles contributed by 27 authors affiliated with more than 12 institutions from 3 countries including Malaysia (Universiti Putra Malaysia), Indonesia (Politeknik Kesehatan Kemenkes Malang; Politeknik Kesehatan Kemenkes Surabaya; Politeknik Kesehatan Kemenkes Yogyakarta; Puskesmas Plaosan Kabupaten Magetan; Rajawali Health Institute, Bandung; Research Group Women and Child Health and Wellbeing, Banyuwangi; Research Group for Animal Biomedical and Conservation, Banyuwangi; RS DR. Sayidiman Magetan; Universitas Airlangga, Banyuwangi), and Bangladesh
This issue consists of 6 articles contributed by 24 authors from 2 countries including Bangladesh and Indonesia.
This issue consists of 6 articles contributed by 28 authors affiliated with more than 6 institutions from 2 countries including Bangladesh and Indonesia.
This issue consists of 6 articles contributed by 20 authors affiliated with more than 8 institutions from 2 countries including Bangladesh (Bangladesh Home Economics College, Center for Multidisciplinary and Contemporary Research, Hajee Mohammad Danesh Science and Technology University, Rangpur Medical College, Maternal and Child Health and Nutrition Research Project of Johns Hopkins University (Bangladesh)) and Indonesia (Politeknik Kesehatan Kemenkes Surabaya, Universitas Airlangga)
This issue consists of 6 articles contributed by 29 authors affiliated with several institutions from 2 countries including Bangladesh (Chattogram Veterinary and Animal Sciences University; Bangladesh Council of Scientific and Industrial Research (BCSIR), Chattogram; Mawlana Bhashani Science and Technology University) and Indonesia (Poltekkes Kemenkes Medan; Politeknik Kesehatan Kemenkes Surabaya)
This issue consists of 6 articles contributed by 23 authors affiliated with several institutions from 2 countries including Bangladesh (Chattogram Veterinary and Animal Sciences University, Bangladesh Council of Scientific and Industrial Research, BCSIR) and Indonesia (Politeknik Kesehatan Kemenkes Surabaya, Teuku Umar University)
This issue consists of 6 articles contributed by 20 authors affiliated with more than 10 institutions from 2 countries including Bangladesh (Chattogram Veterinary and Animal Sciences University) and Indonesia (DP3Ap2KB Kabupaten Sleman Yogyakarta, Politeknik Kesehatan Kemenkes Surabaya, Poltekkes Kemenkes Yogyakarta, Rumah Sakit Umum Daerah Kabupaten Sleman Yogyakarta, STIkes Pasapua Ambon, Tim Audit Kasus Stunting Kabupaten Sleman Yogyakarta, Universitas Kristen Indonesia Maluku, Universitas Mulawarman, Universitas Respati Yogyakarta)
This issue consists of 6 articles contributed by 20 authors affiliated with more than 10 institutions from more than 3 countries including Indonesia (ITSK RS dr. Soepraoen Malang, Politeknik Kesehatan Kemenkes Surabaya, Politeknik Kesehatan Kementerian Kesehatan Yogyakarta, Universitas Airlangga, Universitas Kristen Indonesia Maluku, University of Jember), Jordan (Jordan University of Science and Technology), and Yemen (Al-Jazeera University, Jibla University for Medical and Health Science, Thamar University)
This issue consists of 5 articles contributed by 23 authors affiliated with more than 12 institutions from more than 4 countries including Bangladesh (Maternal and Child Health and Nutrition Research Project of Johns Hopkins University), Indonesia (Airlangga University; Badan Riset dan Inovasi Nasional BRIN; Center of Leather, Rubber, and Plastics, Ministry of Industry, Republic of Indonesia; Indonesian Agency for Meteorology Climatology and Geophysics BMKG; ITSK RS dr. Soepraoen Malang; Syarif Hidayatullah State Islamic University), Pakistan (Government College University Faisalabad; Lyallpur Institute of Advanced Studies Faisalabad; Primary and Secondary Health Care Department Government of Punjab; School and Education Department Government of Punjab; University of Agriculture Faisalabad), and The Gambia (Ministry of Health of The Gambia)
This issue consists of 6 articles contributed by 22 authors affiliated with more than 9 institutions from 3 countries including China (Southern Medical University), Indonesia (Institut Ilmu Kesehatan STRADA Kediri, Politeknik Kesehatan Kemenkes Palangkaraya, Politeknik Kesehatan Kemenkes Surabaya, Politeknik Kesehatan Kemenkes Yogjakarta, ISTeK Insan Cendekia Husada Bojonegoro, Universitas Indonesia, Universitas Surabaya), and Sierra Leone (Directorate of Environmental Health)
This issue consists of 5 articles contributed by 15 authors affiliated with more than 5 institutions from 2 countries including Indonesia (Airlangga University, PGRI University Kediri, Politeknik Kesehatan Kemenkes Surabaya) and Philippines (Visayas State University).
This is the very first issue of Health Dynamics. This issue consists of 5 articles contributed by 21 authors affiliated with more than 5 institutions from 2 countries including Bangladesh (Chattogram Veterinary and Animal Sciences University) and Indonesia (Politeknik Kesehatan Kemenkes Surabaya, STKIP PGRI Indonesia, Wiraraja University)